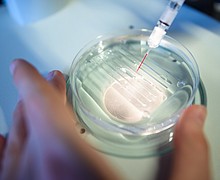

Lawsuit Against the FDA Dismissed in Light of Menthol Rulemaking Process
The plaintiffs in the lawsuit against the FDA – Action on Smoking and Health (ASH), African American Tobacco Control Leadership Council (AATCLC), the American Medical Association (AMA), and the National Medical Association (NMA) – represented by the legal team at …
Exotic Pop, Local Entrepreneur Teaming Up to Help Prevent Child Drownings with FREE Swimming Lessons in Third Ward
Exotic Pop, a Houston, Black-owned beverage company known for their signature sodas and exotic brands, and Imaine Molo, a female CEO and majority owner of KISS Vibe Dining, have teamed up to offer FREE swimming lessons to more than 100 …
Congressman Al Green Helps Secure Over $140 Million for Port of Houston’s Project 11
On Wednesday, June 1, 2022, Congressman Al Green released the following statement:
Mayor Sylvester Turner and Houston Police Department Announce Decrease in Homicide Rates
Mayor Sylvester Turner and the Houston Police Department announced today that for the first time in more than a year, Houston’s homicide rate is showing a decline. As of today, there is an unofficial number of 187 homicides in Houston …
Shell Freedom Over Texas Entertainment Announced
Following two years of a reimagined celebration, the Mayor’s Office of Special Events is thrilled to announce the return of Houston’s Official Fourth of July Celebration, Shell Freedom Over Texas.
A$AP Rocky on the kind of father he wants to be
Just before welcoming a child with Rihanna was earlier this month, A$AP Rocky shared some thoughts about how he planned on approaching fatherhood.
About 100 Sears Hometown stores are closing
Roughly 100 Sears Hometown locations are permanently closing in the coming weeks, representing roughly half of its remaining retail footprint.
K-pop supergroup BTS visits the White House
Korean pop supergroup BTS appeared at the White House press briefing on Tuesday and will meet with President Joe Biden as part of a visit aimed at discussing Asian inclusion and representation and addressing anti-Asian hate crimes and disinformation.
Supreme Court paves way for DOJ to subpoena Texas lawmakers in Voting Rights Act challenge to redistricting maps
The Supreme Court on Tuesday denied an emergency request from three Texas state legislators seeking to quash subpoenas from the US Justice Department and voting rights groups related to a challenge to state legislative maps.
Joe Biden wants to show he's in charge of inflation ... while showing someone else is in charge
President Joe Biden will meet with Federal Reserve Chair Jerome Powell Tuesday in a kind of performative politics that will almost certainly do nothing to help Americans better afford everyday items.
6 steps you can take to quit smoking and live a healthier life
Cigarette smoking is very addictive and can have long-term, adverse health effects. But there is hope for those who want to quit thanks to innovative apps, help lines and proven coping strategies.
Fire and explosions rip through Omaha chemical plant, prompting temporary evacuations
A blaze that sparked explosions and burned part of a chemical plant in Nebraska's most populous city Monday is no longer a threat to the public, a fire official said Tuesday morning.
The remnants of Hurricane Agatha could become Alex this week
After making landfall Monday afternoon as a Category 2 hurricane just west of Puerto Angel, Mexico, Agatha rapidly weakened and is now just a remnant low-pressure system, according to the National Hurricane Center (NHC).
Jill Biden on cover of new issue of Harper's Bazaar
First lady Dr. Jill Biden appears on the cover of the June/July issue of Harper's Bazaar magazine, the first time in the magazine's 155-year history a first lady has appeared on the cover, according to a release from the magazine.
Changing our DNA: 'The age of human therapeutic gene editing is here'
When popular YouTube star Adalia Rose died earlier this year, she looked like a diminutive, sickly woman in her 80s. In reality she was only 15 years old, a victim of progeria, an extremely rare genetic disorder caused by a …